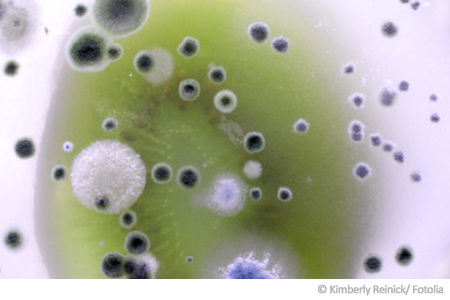

Was ist Schimmel?
Umgangssprachlich werden die Begriffe Schimmel und Schimmelpilze für verschiedene Hyphenpilze verwendet, die als Verderber auf Lebens- und Futtermitteln, sowie auf unterschiedlichen Baustoffen aufzufinden sind.
In diesem Sinn meint Schimmel keinen biologischen Fachbegriff, sondern wird für die oberflächig auf Organismen und Stoffen wachsenden Pilzmyzelien und Sporenträger einiger Pilzgattungen (in der großen Mehrzahl Schlauch- und Jochpilze) benutzt.
In der freien Natur nehmen diese Schimmelpilze eine wichtige Rolle im Stoffkreislauf ein. So ernähren sie sich unter anderem von abgestorbenen Pflanzenresten und tragen auf diese Weise zur Humusbildung bei. Schimmel sind überall auf der Welt zu finden.
➽ Manche Arten der Schimmelpilze haben die Fähigkeit, die Gesundheit des Menschen zu schädigen, andere Arten finden hingegen in der Lebensmittelherstellung und der Medizin Verwendung.
Das Vorkommen von Schimmel in Natur und Wohnbereich
Je nach Gattung können Schimmel bei Temperaturen zwischen 0° C und 60° C wachsen, zusätzlich sind manche Arten sehr widerstandsfähig gegen Trockenheit. Hierdurch erklärt sich ihre weltweite und häufige Verbreitung. Schimmelpilze selbst sind anspruchslos und finden in beinahe allen Böden gute Lebensbedingungen vor. Sie pflanzen sich meist über Sporen fort, die in enormen Mengen an die Luft abgegeben werden.
☝ Auf diese Weise können Schimmelsporen über Distanzen von vielen hundert Kilometern mit dem Wind getragen werden. So gelangen die Schimmelsporen auch in den Wohnbereich des Menschen. Innerhalb unserer Häuser finden Schimmelpilze dann zum Teil ideale Wachstumsbedingungen- etwa, wenn es durch Baumängel oder falsches Lüftungsverhalten zu hohen Luftfeuchtigkeitswerten kommt, oder wir Nahrungsmittel falsch lagern- die Folge ist Schimmel in der Wohnung.
Biologische Definition von Schimmel
Schimmel werden nach den folgenden Eigenschaften definiert und zusammengefasst:
✅ Schimmelpilze leben in der Natur grundsätzlich im Boden
✅ Schimmel sind Saprobionten und ernähren sich durch abgestorbene Substanzen
✅ Schimmelpilze bilden ein Myzel aus
✅ Schimmelpilze vermehren sich durch ungeschlechtliche Sporen
✅ Allenfalls kommt es zu einer geringen Ausbildung von Fortpflanzungsorganen
Folgt man dieser Definition, werden beinahe alle imperfekten Pilze, sowie viele Schlauchpilze und Jochpilze zu den Schimmelpilzen gezählt. Außerdem werden den Schimmelpilzen noch weitere Pilze zugeschlagen, auch wenn diese nicht den genannten Definitionskriterien entsprechen. Ein bekanntes Beispiel für diesen Fall ist der Echte Hausschwamm. Eigentlich ein Ständerpilz, wird diese Art wegen seiner materialzerstörenden Eigenschaften oftmals in die Schimmelpilze eingereiht.
Nutzen und Gefahren durch Schimmelpilze
Schimmelpilze sind vor allem als Krankheits- und Allergieauslöser im Gespräch. Dabei werden Schimmel für die unterschiedlichsten Zwecke mit großem Nutzen eingesetzt.
❗ So wurde zum Beispiel eines der wichtigsten Medikamente der Medizingeschichte erstmals aus der Schimmel-Gattung Penicillium gewonnen: das Antibiotika.
Des weiteren spielen Schimmel in der Nahrungsmittelherstellung eine wichtige Rolle. Sowohl bei der Herstellung des berühmten Roquefortkäse als auch bei der traditionellen Herstellung von Sojasauce werden Schimmelarten eingesetzt. Dem entgegen gelten Schimmelpilze aber hauptsächlich als Schadstoffe für den Menschen. Denn beinahe alle Schimmelpilze können Allergien auslösen, manche produzieren hoch wirksame Giftstoffe oder können bei geschwächten Menschen Infektionen hervorrufen. Außerdem können durch Schimmelbefall ernsthafte Schäden in der Substanz von Gebäuden, Möbeln oder Gemälden verursacht werden.
☝ Ein Schimmeltest kann Ihnen helfen, den Befall besser einschätzen zu können.
Schimmelpilz Schnelltest von airself (6 Räume)
Klicken Sie auf dieses Video und sehen Sie, wie einfach und schnell der Schimmel Test von airself funktioniert!
Durch den airself Schimmelpilz Schnelltest können Sie in der einfachen Heimanwendung bis zu 6 unterschiedliche Räume auf Schimmelpilze untersuchen.
» Der Original airself Schimmel Schnelltest
führt Sie anhand der anschaulichen und leicht verständliche Anleitung
durch alle Schritte der Probenahme bis hin zur Auszählung. Enthalten ist
zudem ein Auswertungs-Schema, umfassende Hintergrundinformationen zu
Schimmelpilz-Ursachen, Gattungen und Maßnahmen sowie Tipps.
» Mehr Details zum airself Schimmelpilz Schnelltest, bitte klicken!
Schimmelanalysen von airself
✔️ Bis zu 6 Räume
✔️ Original airself
✔️ Bis zu 10 Räume
✔️ Original airself
✔️ Bis zu 12 Räume
✔️ Original airself